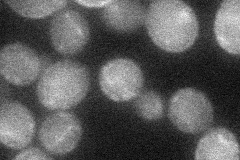
YLR081W
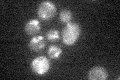
YLR081W
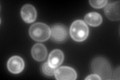
YLR081W

View description
Galactose permease, required for utilization of galactose; also able to transport glucose
Localization:
Intensity:
Fold change:
Significance:
-
C’ GFP library in SD

below threshold17.59 -
N' NOP1pr-GFP in SD

cell periphery50.4017 -
N' TEF2pr-mCherry in SD

missing0 -
N' NATIVEpr-GFP in SD

below threshold14.9042 -
N' TEF2pr-VC and Cyto-VN in SD
cell periphery37.5474 -
C’ GFP library in SD+DTT

cytosol12.730.72No -
C’ GFP library in SD+H2O2
cytosol14.360.81No -
C’ GFP library in Starvation Media

cytosol16.620.94No -
C’ GFP library on the background of Pup2-DaMP
cell periphery, vacuole -
C’ GFP library on the background of CCT mutant

below threshold15.37160.873383No
